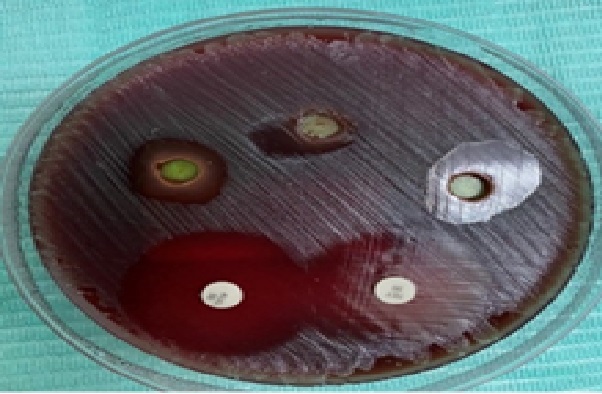
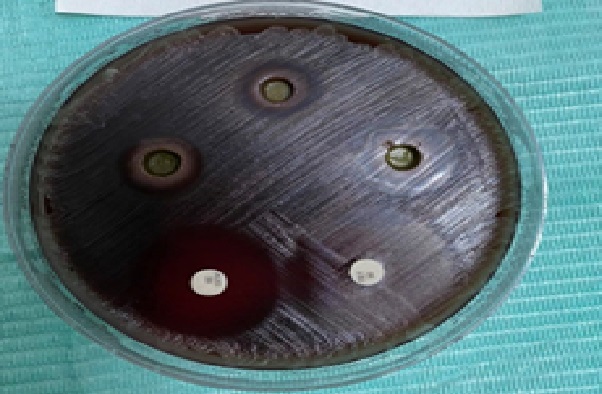
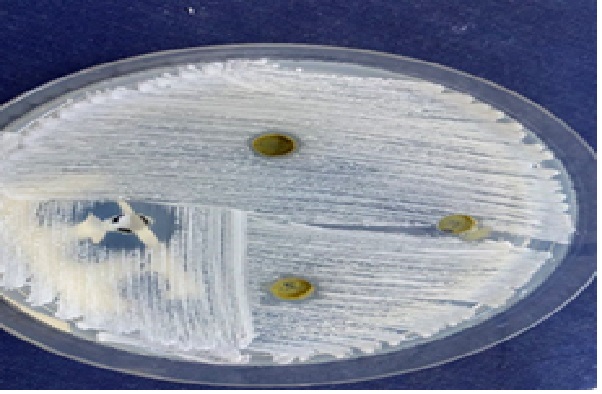

Background: Periodontitis, a severe inflammatory periodontal disease, is a major global health challenge. With the limitations of conventional treatments, phytotherapy using plant materials like Salvia officinalis (sage) presents a promising alternative due to its antimicrobial and anti-inflammatory properties.
Methods: The antimicrobial efficacy of an ethanolic extract of S. officinalis was evaluated using the agar well diffusion method. The extract was tested at concentrations of 25, 50, and 75 mg/ml against five bacterial isolates ( Rothia mucilaginosa , Streptococcus acidominimus , Streptococcus gallolyticus, Arcanobacterium haemolyticum, Gemella morbillorum ) and the fungus Candida albicans . The resulting zones of inhibition were measured and compared statistically to those of the standard antibiotics Tetracycline and Nystatin.
Results: The antimicrobial effect was concentration-dependent and varied by microorganism. The extract showed significant activity against R. mucilaginosa at 50 and 75 mg/ml, with no statistically significant difference from Tetracycline (P = 0.132). Similarly, against S. acidominimus , all three concentrations were effective without a significant difference from the antibiotic. In contrast, the extract's effect on S. gallolyticus , A. haemolyticum , and G. morbillorum was significantly lower than Tetracycline (P = 0.000). The effect on C. albicans was also significantly lower than Nystatin (P = 0.000).
Conclusion: Salvia officinalis ethanolic extract possesses selective and concentration-dependent antimicrobial activity. It shows particular efficacy against specific oral bacteria like R. mucilaginosa and S. acidominimus , comparable to a standard antibiotic. This supports its potential as a complementary phytotherapeutic agent for managing periodontitis, although its effectiveness is not universal across all associated pathogens.
Periodontitis, Periopathogens, R.mucilaginosa, S.acidominimus, Strept.gallolyticus, Gemella morbillorum , Arcanobacterium heamolyticum, and C. albicans, Salvia officinalis, Sage, Antimicrobial, Antibacterial, antifungal
The mouth is colonized by microorganisms a few hours after birth, mainly by aerobic and facultative anaerobic micro-organisms. The eruption of teeth allows the development of a complex ecosystem of microorganisms. More than 700 different species can colonize the mouth and over 400 species may be found in periodontal pockets [1]. Periodontal disease is the result of infections that lead to inflammation and tissue damage in the structures surrounding the teeth. The prevalence of periodontal disease in Libyan subjects was 75.7% according to Fadilla and Sutan [2]. A study by Peeran, et al. shows that more than half of the adult population in Sebha-Libya are detected with signs of destructive periodontitis [3].
Infectious diseases still represent a major threat to public health. At present, there are many antimicrobial drugs which saved millions of human lives and killed incalculable number of microbes both pathogenic and commensal. However, with increasing use of antibiotics now we are facing not only an increasing threat of antibiotic resistance but also with arising concern about the potential long term effect of antibiotics on human health, as they are implicated in disruption of gut microbiom, obesity, type two diabetes, inflammatory bowel disease IBD, anxiety, autism, allergies and autoimmune diseases [4].
The medicinal plants are becoming increasingly popular to be used for a wide variety of purposes, because of the antibiotic exhibited some problems such as prolonged systemic therapy, microbial resistance, high toxicity, high cost and relative unavailability of medicines in developing countries. For these reasons, Herbal medicine is practiced today in different countries around the world. Some of the advantages of herbs over the formulated drugs are those that typically have fewer side effects, they are inexpensive and readily available. Medicinal plants have been a source of bioactive compounds to treat many diseases. Traditionally used medicinal plants produce a variety of compounds with known therapeutic properties [5].
Sage ( Sal v ia officinalis /Lamiaceae) is widely used in folk medicine, cosmetics, phytopharmacy, and the flavoring of food products. Sage mouth rinse can be used as an adjunct for conventional methods of plaque control against dental plaque [6]. The existence of some compounds such as; Tojun, Cineol, and Camphor in Salvia essential oil is responsible for its antimicrobial and antioxidant properties [7].
The isolates of oral pathogens used in current study have been obtained from patients attending Al-Hureyat polyclinic centre (Zliten-Libya), in the period from September to November 2021. All subjects undergo a thorough oral examination. The screening procedures included questions regarding personal data, dental and medical history, and intraoral and extraoral examination were recorded within patient questionnaires. Periodontopathogens samples have been collected from a dental clinic. Patients diagnosed with periodontitis according to: (A) bleeding on probing (BOP) referred by the sulcus bleeding index (scored as 0 = no bleeding; 1 = point bleeding within 30 seconds; 2 = immediate overt bleeding). (B) Pocket depth PD (the measurements were rounded off to the nearest millimeter marking on periodontal probe). (C) The clinical attachment loss CAL was recorded at the sample sites (by measuring the distance from the cemento-enamel junction to the bottom of the pocket). (D) Tooth mobility.
Fifteen subjects have been diagnosed with moderate to severe periodontitis. The periodontally affected population fulfilled the following selection criteria: 1)-periodontal disease with pocket probing depth of PPD ≥ 2 mm. 2)-clinical attachment loss AL ≥ 5 mm. 3)-presence of bleeding on probing BOP. 4)-presence at least twelve teeth [8].
The samples were collected by the paper point method as mentioned by Décaillet, et al . and inoculated on specific media for aerobic and anaerobic cultures [9]. Then transported to the laboratory of Zliten medical centre.
Sage (Salvia officinalis) is a perennial and herbaceous plant species, belongs to the Lamiaceae family, and has a strong root system and 40-50 cm height native to the Middle East and Mediterranean regions. Dried leaves are the raw material for nutritional, pharmaceutical, and essence products which can be applied for diseases related to nervous system, cardiovascular system and respiratory diseases [7]. The dried leaves of Salvia officinalis were obtained from herbs store in Zliten, and then grinded into a powder by a grinder. Then placed in dark glass bottles as a powder for subsequent studies.
Powder of S. officinalis’s leaves has been extracted according to the method of Recio, et al. where about 20 g powder of dried Salvia officinalis’s leaves was added to 200 ml of 96% ethanol separately, then the mixture was agitated and put on Shaker apparatus, lifted for 48 hrs. Then filtrated. The mixtures have been evaporated on rotary evaporator apparatus, under reduced pressure at 40°C [10]. The extracts were further dried at room temperature after which they collected in sterile capped bottles and stored. An amount of 1g from dried extract dissolved in 10 ml distilled water to obtain stock solution of 100 mg/ml and the solution was further diluted to give concentrations of 25 mg/ml, 50 mg/ml, and 75 mg/ml; those concentrations have been subjected to antimicrobial assay.
Antimicrobial assay of extracts against periodontopathogens: The antibacterial assay of the selected isolates was carried out by agar wells diffusion method mentioned by [11,12]. The antimicrobial assay was came out by using three different concentrations 25 mg/ml, 50 mg/ml, and 75 mg/ml of ethanolic extracts of S. Officials’s leaves, they were tested against 5 bacterial strains by the agar-well diffusion method. Tetracycline and Augmentin were used as a positive control. After isolation and identification of many bacterial species, five bacterial isolates were recruited for further study, which are; Rothia mucilaginosa , streptococcus acidominimus, Streptococcus gallolyticus, Arcanobacterium heamolyticum, Gemella morbillorum . A bacterial inoculum were prepared in distilled water and were plated onto blood agar and spread in three directions by sterile swabs. After the bacterial culture was uniformly cultured on surface of Blood agar. The wells with diameter of 6mm were created using a sterile Pasteur pipette; three wells in each blood agar plate were done. Then, 25 μl each extract concentrations were poured into each well. The diameter of growth inhibition zone was measured after 18-24 hours of incubation at 37°C. Each experiment was repeated five times for each bacterial strain. Mean diameter of inhibition zone of the five replicates was recorded.
Antimicrobial assay of ethanolic extracts against C. albicans
The anti-candidal activity of S. Officials ethanolic extracts were assayed against C. albicans isolates by agar well diffusion according to Perez, et al. method [13]. One hundred microliters of yeast inoculum was uniformly spread onto Sabouraud dextrose agar with Chloramphenicol and Gentamicin (CONDA ® ), then four wells 6 mm diameter were punched by a pasture pipette into SDA medium and filled with 25 μl of three- fold serial dilutions 25 mg/ml, 50 mg/ml, 75 mg/ml of plant extract as well as 25 μl of 100.000 IU/ml Nystatine as a positive control. The plates were incubated for 24 hours at 37°C. Anti-Candida activity was determined by measuring the zone of inhibition [14]. The experiments were carried out five times. Mean diameter of inhibition zone of the five replicates was recorded.
The antimicrobial assay data were analyzed by kruskal-walis test, when a test of Normality (Kolmogorov-Smirnova and Shapiro-Wilk) exhibited high significant levels, Nonparametric Tests were depended. The least significant difference test LSD, using SPSS software (version 25). P-value less than 0.05 was considered as statistically significant.
The effect of ethanolic extract of S. officinalis against periodontopathogens (Table 1) was dependent on bacterial species and the dose of extract, hence, with the increasing concentration of the ethanolic S. officinalis extract, the bacterial growth has decreased, whereas the inhibition zone has increased.
Table 1: Density grades in male group. View Table 1
Both S. officinalis ethanolic extract 75 mg/ml and 50 mg/ml concentrations showed the zones of inhibition with mean of 13 mm on R. mucilaginosa plates (Figure 1), and they exhibited a good antibacterial effect without a statistically significant difference when compared with Tetracycline ( P = 0.132) and Augmentin ( P = 0.109) antibiotics. Nevertheless, 25 mg/ml concentration showed (10.4 mm) inhibition zones mean and low antibacterial activity when compared with Tetracycline ( P = 0.032) and Augmentin ( P = 0.029). Moreover, on S. acidominimus plates too (Figure 2). The concentrations 25 mg/ml, 50 mg/ml and 75 mg/ml of the S. officinalis ethanolic extracts showed mean of inhibition zones 11.2 mm, 13 mm and 13.6 mm respectively and exhibited good antibacterial effect without statistically significant difference when compared with tetracycline. On the other hand, when compared with Augmentin, the S. officinalis ethanolic extract of 25 mg/ml, 50 mg/ml and 75 mg/ml concentrations showed low levels of antibacterial effects and a statistically significant difference were P = 0.001, P = 0.004, P = 0.006 respectively.
Figure 1: The effect of sage ethanolic extract with different concentrations on R.mucilaginosa.
View Figure 1
Figure 1: The effect of sage ethanolic extract with different concentrations on R.mucilaginosa.
View Figure 1
Figure 2: The effect of sage ethanolic extract with different concentrations on S. acidominimus.
View Figure 2
Figure 2: The effect of sage ethanolic extract with different concentrations on S. acidominimus.
View Figure 2
Although the effect of S. officinalis ethanolic extract 25 mg/ml, 50 mg/ml and 75 mg/ml concentrations show means of inhibition zones of 9 mm, 13 mm and 13.8 mm respectively but they exhibited statistically significant difference with Tetracycline and Augmentin P = 0.00 on both (Figure 3) A. heamolyticum (Figure 4) and G. morbillorum .
 Figure 3: The effect of sage ethanolic extract with different concentrations on A. heamolyticum.
View Figure 3
Figure 3: The effect of sage ethanolic extract with different concentrations on A. heamolyticum.
View Figure 3
 Figure 4: The effect of sage ethanolic extract with different concentrations on G.morbillorum.
View Figure 4
Figure 4: The effect of sage ethanolic extract with different concentrations on G.morbillorum.
View Figure 4
Different concentrations of S. officinalis ethanolic extract 25 mg/ml, 50 mg/ml, and 75 mg/ml showed mean of inhibition zones of 6.4 mm, 8.8 mm, and 9.6 mm respectively on S. gallolyticus , with statistically significant difference P = 0.000 for both Tetracycline and Augmentin.
The antimicrobial effect of ethanolic S. officinalis extract has been tested against some bacteria that isolated from periodontal pockets; the results indicated that S. officinalis has a good antibacterial effect against R. mucilaginosa and S. acidominimus at 75 mg/ml and 50 mg/ml, in contrast to 25 mg/ml concentration. This can be attributed to the low concentration of active substances in low concentrations and therefore less antibacterial effect. On the other hand, sage ethanolic extract do not exhibit antibacterial effect on (Figure 5) S. gallolyticus and A. heamolyticum .
 Figure 5: The effect of sage ethanolic extract with different concentrations on S. gallolyticus.
View Figure 5
Figure 5: The effect of sage ethanolic extract with different concentrations on S. gallolyticus.
View Figure 5
Gemella morbillorum ( G. morbillorum ) is a multidrug resistant (MDR) human pathogens, which is resistant to 14 different antibiotics; Tetracycline, vancomycin, piperacillin, clindamycin, trimethoprim, sulfomethoxazole, oxacillin, azactam, flucloxacillin, ampicillin, gentamycin, chloramphenicol, erythromycin, rifampicin and ciprofloxacin-resistant, and its tobramycin and bacitracin-intermediate, and amikacin-sensitive; That may be attributed to low extract volume that has been used in the study [15]. A study of El-Sayed, et al . pointed on the effect of sage extract on G. morbillorum which exhibited a weak antibacterial effect of sage on mentioned bacteria, as well as, this study revealed.
According to the result shown in (Table 2), the three concentrations of sage ethanolic extract 25 mg/ml, 50 mg/ml, and 75 mg/ml illustrated inhibition zone of means 6.2 mm, 6.4 mm, and 7.4 mm respectively, and significance levels were P = 0.000 when they were compared with Nystatine (Figure 6).
Figure 6: The effect of sage ethanolic extract with different concentrations on C. albicans compared with nystatine.
View Figure 6
Figure 6: The effect of sage ethanolic extract with different concentrations on C. albicans compared with nystatine.
View Figure 6
Table 2: The effect of sage ethanolic extract with different concentrations on C. albicans compared with Nystatin. View Table 2
In agreement with, more S. officinalis concentration extract is required for antifungal activity to be realized; our results show low antifungal effect of S. officinalis extract [16]. Nevertheless, this does not agree with De Oliveira, et al. that clarified S. officinalis extract showed an effective antimicrobial action on C.albicans and the reason that antimicrobial effect presented by S officinalis attributed to the presence of numerous bioactive compounds in this plant. Among the most important molecules identified are α-thujone (34.7%), camphor (23.5%), 1, 8-cineole (11.5%), and carvacrol (7.4%) [17].
Sage is widely used in folk medicine, cosmetics, phytopharmacy, and the flavoring of food products. Sage mouth rinse can be used as an adjunct for conventional methods of plaque control against dental plaque. The ethanolic extract of sage exhibited a good antibacterial effect on R. mucilaginosa . On S. acidominimus; sage exhibited good antibacterial effect without a significant difference when compared with tetracycline. On other hand, the effect of sage on S.gallolyticus, A. heamolyticum and G. morbillorum exhibited statically significant difference P = 0.000. As well as with C. albicans. Therefore the results reveal that the effect of ethanolic extracts was depend on microorganisms' species and extract concentration.
The authors would like to express their deep thanks to all whom helped in this study.